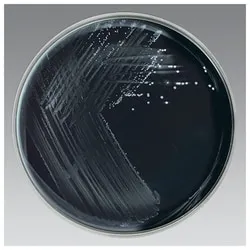
Bordetella pertussis culture on Regan-Lowe charcoal agar

Microbiology & Virulence - The Whoop-There-It-Is Bug
- Organism: Encapsulated, gram-negative coccobacillus. Strictly aerobic & fastidious.
- Culture: Requires specialized media for growth:
- Bordet-Gengou agar (potato-based).
- Regan-Lowe medium (charcoal, blood, antibiotic).
- Key Virulence Factors:
- Filamentous Hemagglutinin (FHA): Mediates adherence to ciliated respiratory epithelium.
- Pertussis Toxin (PT): ADP-ribosylates Giα, disabling it → massive ↑cAMP.
- Adenylate Cyclase Toxin: Exogenous, calmodulin-activated adenylate cyclase → ↑cAMP.
- Tracheal Cytotoxin: Peptidoglycan fragment toxic to ciliated epithelial cells.
⭐ Pertussis toxin (PT) disables Gi proteins, the inhibitory G-protein, leading to uninhibited adenylate cyclase activity. The resulting surge in cAMP is responsible for the profound lymphocytosis seen in patients.

Pathogenesis & Clinical Stages - The 100-Day Cough
- Attachment: Bacteria adhere to the respiratory ciliated epithelium using adhesins like filamentous hemagglutinin and pertactin.
- Toxin-Mediated Damage:
- Pertussis Toxin (PT): Disables Gi proteins → massive ↑ cAMP. This impairs immune cell function and causes profound lymphocytosis.
- Adenylate Cyclase Toxin: An invasive enzyme that directly increases intracellular cAMP.
- Tracheal Cytotoxin: A peptidoglycan fragment that is directly toxic to ciliated epithelial cells, causing ciliostasis and their extrusion.
⭐ Pertussis Toxin prevents lymphocytes from entering lymphoid tissues, causing a dramatic peripheral lymphocytosis (WBC >20,000/μL) instead of the neutrophilia typical of bacterial infections.
Diagnosis & Treatment - Taming the Whoop
-
Diagnosis:
- Gold Standard: PCR from a nasopharyngeal swab is preferred for its speed and sensitivity.
- Culture: Requires specialized media like Bordet-Gengou or Regan-Lowe charcoal agar.
- Labs: Classic finding is a dramatic ↑ in white blood cells, with marked lymphocytosis.
-
Treatment:
- Antibiotics: Macrolides (e.g., Azithromycin) are the drugs of choice. Crucial to treat early.
- Prophylaxis: Treat all close contacts, regardless of immunization status.
- Supportive care is vital, especially in infants.
⭐ Pertussis toxin causes the profound lymphocytosis by preventing lymphocytes from entering lymphoid tissue.
Prevention - Vaccine Vanguard
- Acellular Vaccines (aP):
- DTaP: For children < 7 years old. Contains more pertussis antigens.
- Tdap: Booster for adolescents (age 11-12) and adults. Recommended for all healthcare workers.
- Chemoprophylaxis: For close contacts; macrolides (e.g., azithromycin) are effective in preventing disease after exposure.
⭐ Tdap is recommended during each pregnancy, ideally between 27-36 weeks, to provide passive immunity to the newborn.
High‑Yield Points - ⚡ Biggest Takeaways
- Bordetella pertussis is a Gram-negative coccobacillus that causes whooping cough.
- It attaches to the respiratory epithelium via filamentous hemagglutinin.
- Pertussis toxin ADP-ribosylates G_i_, disabling it and leading to a massive ↑ in cAMP, causing lymphocytosis.
- The clinical course has three stages: catarrhal, paroxysmal, and convalescent.
- Culture requires special media: Bordet-Gengou or Regan-Lowe agar.
- Treatment is primarily with macrolides.
Unlock the full lesson and continue reading
Signup to continue reading this lesson and unlimited access questions, flashcards, AI notes, and more